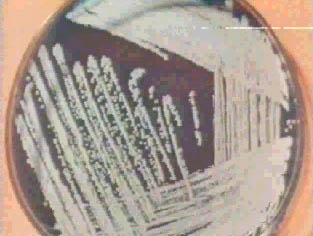

海博微信公众号
海博天猫旗舰店




1、平板划线分离法
用接种环以菌操作沾取少许待分离的材料,在无菌平板表面进行平行划线、扇形划线或其他形式的连续划线 ,如果划线适宜的话,微生物能一一分散,经培养后,可在平板表面得到单菌落。
2、稀释倒平板法
3、单孢子或单细胞分离法
采取显微分离法从混杂群体中直接分离单个细胞或单个个体进行培养以获得纯培养 。
在显微镜下使用单孢子分离器进行机械操作,挑取单孢子或单细胞进行培养。也可以采用特制的毛细管在载玻片的琼脂涂层上选取单孢子并切割下来,然后移到合适的培养基进行培养。
4、选择性培养基分离法
各种微生物对不同的化学试剂、染料、抗生素等具有不同的抵抗能力,利用这些特性可配制合适某种微生物而限制其它微生物生长的选择培养基,用它来培养微生物以获得纯培养。
微生物纯培养分离方法的比较
上一篇:冰激凌里的杀人菌 李斯特菌
下一篇:免疫学检测技术
